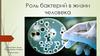
Роль бактерий в жизни человека

Similar presentations:
Роль бактерий в жизни человека
1.
Роль бактерий в жизни человекаАвтор Галанов С.А, ученик 10"А" класса
МБОУ "Новоляденской СОШ"
Руководитель Ворожейкина А.А, учитель
естествознания
2.
Актуальность• Тема, очень актуальна, потому что в нашей жизни мы
часто слышим от взрослых: не ешь немытые фрукты,
подцепишь какую-нибудь бактерию или мойте руки
перед едой, а то на руках много заразных микробов.
Складывается впечатление, что бактерии несут только
вред человеку, однако мой проект помогает сделать
вывод, что бактерии бывают не только плохие, но и
хорошие.
3.
Цель работы:• Изучить что такое бактерии. Какие бывают
полезные и патогенные бактерии, найти
молочнокислые бактерии в кисломолочных
продуктах.
Задачи:
-Ознакомиться с характеристикой бактерий.
-Узнать в какой среде обитают бактерии.
-Изучить роль изучить роль бактерий в жизни людей.
Методы исследования:
1.Сбор информации о бактериях.
2.Анализ полученной информации.
3.Заключение.
4.
Кто впервые открыл и описал бактерии?Впервые бактерий увидел в
оптический микроскоп и описал в
1676 году голландский
натуралист Антони ван Левенгук.
Как и всех микроскопических
существ, он назвал их
«анималькули». Название
«бактерии» ввёл в употребление в
1828 году Христиан Эренберг.
24 октября 1632 – 26 августа 1723 гг.
5.
• Теория:Бактерии — одноклеточные микроорганизмы (микробы), у
которых нет оформленного клеточного ядра. Это самый
распространенный вид живых организмов, которые обитают
на Земле.
6.
Палочки(бациллы)
Кокки
Вибрионы
Спириллы
7.
Кишечная палочкаКишечная палочка – это факультативноанаэробная грамотрицательная подвижная
палочковидная бактерия.
8.
Полезные бактерии в организме человека:Лактобактерии
они же лактобациллы, являются, по
сути, первыми микроорганизмами,
с которыми сталкивается человек в
своей жизни.
Бифидобактерии
из всех бактерий именно они
обладают
наиболее значительным представ
ительством в организме человека.
9.
ЗаключениеБактерии - простые одноклеточные микроскопические
организмы, которые очень важны человеческому
организму, и в целом всем живым организмам. Без них
некоторые процессы могут быть нарушены. И поэтому без
них нам ни как.
10.
Спасибо за вниманиеСписок сайтов с которых была взята информация:
1.http://biouroki.ru/material/plants/bakterii.html
2.http://ru.wikipedia.org/
3.http://www.eurolab.ua/anatomy/272/
4.https://natworld.info/raznoe-o-prirode/samye-interesnye-i-uvlekatelnye-fakty-pro-bakterij
5.Большая книга ВОПРОСОВ и ОТВЕТОВ «ЧТО? ЗАЧЕМ? ПОЧЕМУ?».
6.Компьютерная энциклопедия – УМНИКИ «Изучаем Планету».
7.Материал из Википедии — свободной энциклопедии
8.Природа Мира|NatWorld.info
9.С.А.Павлович «Микробиология с микробиологическими исследованиями». Учебное
пособие. Минск: Высш. шк., 2009.-502с.
10.Сайт Фирма Мир - http://farmamir.ru/2011/11/vidy-bakterij-xoroshie-i-ploxie2/http://forexaw.com
11.https://yandex.ru/images/search?from=tabbar&text=яндекс%20картинки%20бактерии
12.https://probakterii.ru/prokaryotes/raznoe/kto-opisal-bakterii.html
13.https://ru.wikipedia.org/wiki/Бифидобактерии
14.https://vitafarma.ru/spost/vsyo-o-laktobakteriyah/










 biology
biology